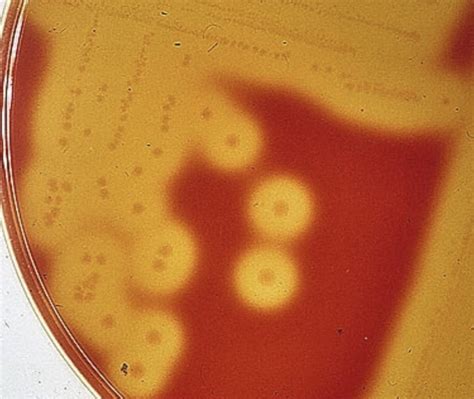

If you are looking for Beta Hemolysis you've come to the right place. We have 28 images about Beta Hemolysis including images, pictures, photos, wallpapers, and more. In these page, we also have variety of images available. Such as png, jpg, animated gifs, pic art, logo, black and white, transparent, etc.

Not only Beta Hemolysis, you could also find another pics such as
Blood Agar Plate,
Staph Aureus,
Blood Agar,
Catabolite Repression,
Strep Throat Culture,
Sheep Blood Agar,
Bacterial Colonies,
Blood Agar Colonies,
Wide Zone,
Pseudomonas Blood Agar,
Agar Plate,
Mac Plate,
Bacitracin,
Clear Zone,
and Strong.
 1500×1225 beta hemolysis images stock vectors shutterstock from www.shutterstock.com
1500×1225 beta hemolysis images stock vectors shutterstock from www.shutterstock.com
 1024×640 alpha hemolysis beta hemolysis whats difference from www.askdifference.com
1024×640 alpha hemolysis beta hemolysis whats difference from www.askdifference.com
 320×320 beta hemolysis gamma hemolysis scientific diagram from www.researchgate.net
320×320 beta hemolysis gamma hemolysis scientific diagram from www.researchgate.net
 1500×1101 beta hemolysis royalty licensable stock from www.shutterstock.com
1500×1101 beta hemolysis royalty licensable stock from www.shutterstock.com
 700×486 solved plate shows beta hemolysis alpha hemolysis cheggcom from www.chegg.com
700×486 solved plate shows beta hemolysis alpha hemolysis cheggcom from www.chegg.com
 612×607 beta hemolysis stock pictures royalty images istock from www.istockphoto.com
612×607 beta hemolysis stock pictures royalty images istock from www.istockphoto.com
 601×535 answered beta hemolysis hemolysis alpha bartleby from www.bartleby.com
601×535 answered beta hemolysis hemolysis alpha bartleby from www.bartleby.com
 960×720 beta hemolytical streptococci beta hemolysis blood descubra from www.cnss.gov.lb
960×720 beta hemolytical streptococci beta hemolysis blood descubra from www.cnss.gov.lb
 525×700 solved alpha hemolysis beta hemolysis gamma cheggcom from www.chegg.com
525×700 solved alpha hemolysis beta hemolysis gamma cheggcom from www.chegg.com
 1104×813 beta hemolysis blood kingstongromelton from kingstongromelton.blogspot.com
1104×813 beta hemolysis blood kingstongromelton from kingstongromelton.blogspot.com
 1347×704 solved type hemolysis shown picture cheggcom from www.chegg.com
1347×704 solved type hemolysis shown picture cheggcom from www.chegg.com
 550×500 difference alpha beta hemolysis definition process from pediaa.com
550×500 difference alpha beta hemolysis definition process from pediaa.com
 1575×2100 beta hemolysis blood koenqocline from koenqocline.blogspot.com
1575×2100 beta hemolysis blood koenqocline from koenqocline.blogspot.com
 1136×852 beta hemolysis blood rigobertotarogreene from rigobertotarogreene.blogspot.com
1136×852 beta hemolysis blood rigobertotarogreene from rigobertotarogreene.blogspot.com
 1500×1479 beta hemolysis bacterial colonies sheep stock photo from www.shutterstock.com
1500×1479 beta hemolysis bacterial colonies sheep stock photo from www.shutterstock.com
 780×585 hemolysis trialquest from www.trialexhibitsinc.com
780×585 hemolysis trialquest from www.trialexhibitsinc.com
 2006×1649 solved beta alpha gamma hemolysis cheggcom from www.chegg.com
2006×1649 solved beta alpha gamma hemolysis cheggcom from www.chegg.com
 1600×1156 hemolysis cartoons illustrations vector stock images pictures from cartoondealer.com
1600×1156 hemolysis cartoons illustrations vector stock images pictures from cartoondealer.com
 700×693 solved microbiology interpret type hemolysis alphabetaor from www.numerade.com
700×693 solved microbiology interpret type hemolysis alphabetaor from www.numerade.com
 700×693 solved interpret type hemolysis alpha beta cheggcom from www.chegg.com
700×693 solved interpret type hemolysis alpha beta cheggcom from www.chegg.com
 3023×3023 alpha beta gamma hemolysis rmicrobiologyobsession from www.reddit.com
3023×3023 alpha beta gamma hemolysis rmicrobiologyobsession from www.reddit.com
750×632 solved type hemolysis cheggcom from www.chegg.com
750×632 solved type hemolysis cheggcom from www.chegg.com
 700×526 solved hemolysis shown picture cheggcom from www.chegg.com
700×526 solved hemolysis shown picture cheggcom from www.chegg.com
 700×503 solved type hemolysis pictured beta cheggcom from www.chegg.com
700×503 solved type hemolysis pictured beta cheggcom from www.chegg.com
 1170×2532 cool beta hemolysis caught eye rmedlabprofessionals from www.reddit.com
1170×2532 cool beta hemolysis caught eye rmedlabprofessionals from www.reddit.com
 1211×1488 alpha hemolysis tabitha johnson blog from storage.googleapis.com
1211×1488 alpha hemolysis tabitha johnson blog from storage.googleapis.com
 1024×512 solved difference alpha beta hemolysis from www.numerade.com
1024×512 solved difference alpha beta hemolysis from www.numerade.com
 2048×1152 hemolysis blood abhijith from www.slideshare.net
2048×1152 hemolysis blood abhijith from www.slideshare.net
Don't forget to bookmark Beta Hemolysis using Ctrl + D (PC) or Command + D (macos). If you are using mobile phone, you could also use menu drawer from browser. Whether it's Windows, Mac, iOs or Android, you will be able to download the images using download button.